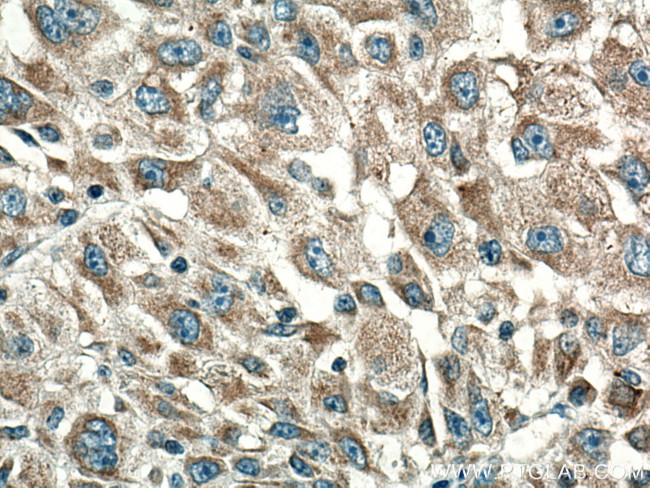
CYR61 Antibody in Immunohistochemistry (Paraffin) (IHC (P))

Search
Proteintech
CYR61 Monoclonal Antibody (2E11F11)
{{$productOrderCtrl.translations['antibody.pdp.commerceCard.promotion.promotions']}}
{{$productOrderCtrl.translations['antibody.pdp.commerceCard.promotion.viewpromo']}}
{{$productOrderCtrl.translations['antibody.pdp.commerceCard.promotion.promocode']}}: {{promo.promoCode}} {{promo.promoTitle}} {{promo.promoDescription}}. {{$productOrderCtrl.translations['antibody.pdp.commerceCard.promotion.learnmore']}}
产品信息
67656-1-IG
种属反应
宿主/亚型
分类
类型
克隆号
抗原
偶联物
形式
浓度
规格
纯化类型
保存液
内含物
保存条件
运输条件
产品详细信息
Aliquoting is unnecessary for -20°C storage.
靶标信息
CYR61 is a secreted heparin binding protein, encoded by a growth factor inducible immediate-early gene that associates with the extracellular matrix and connective tissue. CYR61 is a member of a distinct family of angiogenic and vasculogenic regulators designated CCN proteins, which includes connective tissue growth factor (CTGF) and the mouse CYR61 homolog, Fisp12. As an angiogenic inducer, CYR61 binds to the cell surface receptor integrin alphavbeta3, where it then stimulates cell adhesion and migration and promotes DNA synthesis of human vascular endothelial cells. Expression of CYR61 is elevated during vessel growth, wound healing and chondrocyte differentiation. CYR61 is also detected in a wide variety of tumors as it induces tumor growth and functions as a marker of tumor progression.
仅用于科研。不用于诊断过程。未经明确授权不得转售。
生物信息学
蛋白别名: CCN family member 1; Cellular communication network factor 1; CYR61; cysteine rich angiogenic inducer 61; Cysteine-rich angiogenic inducer 61; cysteine-rich heparin-binding protein 61; cysteine-rich, anigogenic inducer, 61; IBP-10; IGF-binding protein 10; IGFBP-10; Insulin-like growth factor-binding protein 10; Protein CYR61; Protein GIG1; tumor RMS cell line RD specific product; unnamed protein product
基因别名: CCN1; CYR61; GIG1; IGFBP10
UniProt ID: (Human) O00622
Entrez Gene ID: (Human) 3491